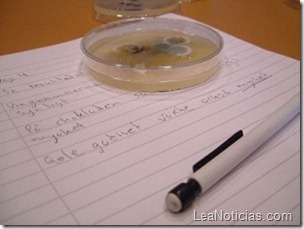

Por si no estabas enterado, cientos de bacterias habitan nuestros intestinos, influenciando nuestra fisiología y nuestra salud en maneras que recién se están descubriendo. Uno de esos nuevos descubrimientos es que estas bacterias pueden también influenciar nuestra mente, alterando la química del cerebro y cambiando el ánimo y el comportamiento.
El interés científico por la flora bacteriana ha aumentado en los últimos años. Hasta ahora, los estudios se habían enfocado en agentes patógenos que pudieran influenciar al cerebro liberando toxinas o estimulando al sistema inmune. Un nuevo estudio, sin embargo, sugiere que también las bacterias benignas pueden alterar la mente.
El neurocientífico John Cryan, de la University College Cork en Irlanda, junto a colegas de la McMaster University en Canadá, le dieron a un grupo de ratones un grupo de bacterias benignas, llamadas Lactobacillus rhamnosus – como un yogurt Activia sobrecargado. Eligieron estas bacterias porque tenían muchas y porque son un ingrediente común en los suplementos probióticos que se venden en el mercado, de los que no se conoce mucho cuáles podrían ser los efectos secundarios.
En este caso, los efectos parecieron ser beneficiosos. Los ratones alimentados con el suplemento por 6 semanas estaban menos estresados y con menos ansiedad que los ratones alimentados normalmente. Por ejemplo, los ratones pasaron más tiempo explorando pasillos angostos y espacios abiertos, que suelen darle miedo a los roedores. También mostraron una menor alza de las hormonas del estrés cuando los investigadores los metieron en agua. “Esto es emocionante porque nos muestra que los animales están más relajados y no crean la misma respuesta estresante”, dice Cryan.
Analizando los cerebros de los ratones con suplementos bacterianos, los investigadores encontraron cambios en la actividad de los genes responsables de codificar partes de los receptores que reciben la información de los neurotransmisores GABA. Este tipo de neurotransmisores normalmente reducen la actividad neuronal, y muchas drogas que tratan la ansiedad tienen como objetivo este tipo de receptores.
Los investigadores descubrieron que la influencia de las bacterias se produce a través del nervio vago, aunque todavía no se sabe cómo, lo que será el próximo paso a investigar.
El estudio sugiere que uno podría cambiar los estados de ánimo regulando la flora intestinal, lo que podía ayudar a tratar a personas con problemas de cambio de ánimo, por ejemplo. Así que ojo con los yogures que se tomen.
[Fuente]
